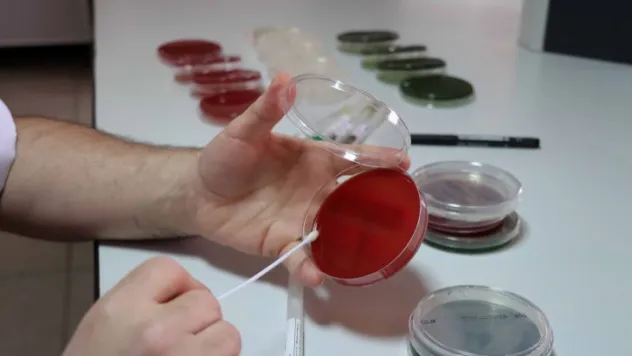
Skretting Türkiye'nin Balık Sağlığı ve Refahı Hizmetleri

Sağlık
Skretting Türkiye'nin Balık Sağlığı ve Refahı Hizmetleri

Kinoa Faydaları Nelerdir? Ne Kadar Tüketmeliyiz?

Tırnak Yeme Sorununa Dikkat! Kendimize Nasıl Engel Oluruz?

Deprem Sonrası Acil Servislerde Vertigo Şikâyeti Artış Gösterdi

Vücutta Oluşan Ödeme Dikkat

Obez bireylerin oranı yüzde 20,2 oldu

Stres Yapmanın Kalp Sağlığına Etkilerine Dikkat!

Yağ Eriten Besinler ve İçecekler

Çocuklar İçin Açık Hava Etkinliği Düzenlendi

Anne Babalar da Oyun Oynar

Stresin Olumsuz Etkilerine Dikkat!

Kalp Sağlığına Zarar Veren Durumlara Dikkat

Vücuttaki Yanık İzlerine Dikkat! Yanık İzleri Geçer mi?

Şeker Katkısı Yapılmış İçeceklerin Tüketilmesine Dikkat

Beyin Sağlığına Dikkat! Beyin Sağlığımız İçin Özel Besinler

Covid-19 sona erdi!

Gözde Sıtmapınarı Hastanesi yeniden hizmete başladı

Damar Sertliği Neden Olur? Nelere Dikkat Edilmeli? Nelerden Uzak Durulmalı?

TÜBİTAK Aşı ve İlaç Geliştirme Kampüsü için bilim insanlarına çağrı

Aile İçi Tartışmaların Çocuklar Üzerine Etkisine Dikkat!

Neden Kaygılı Oluruz? Kaygılı Olmanın Belirtileri Nelerdir? Nelere Dikkat Etmeliyiz?

Yeni tip ŞAP aşısı 4,5 milyon hayvana uygulandı.

Adaçayı Nedir, Faydaları Nelerdir, Nasıl Demlenir?

Vücuttaki İltihaplara Dikkat!

Manipüle Edilmeye Dikkat! Manipülasyon nedir?

Neden rüya görürüz? Kabus görürsem ne yapmalıyım?

Sinirlilik ve tahammülsüzlük nedir? Son dönemde arttı mı?

Mavi Işık Nedir? Tehlikeleri Nelerdir?

Hasta İle Hekim bir ekibin vazgeçilmez iki tarafıdır

Anne Karnındaki Bebeğinizle Konuşabilirsiniz

TÖTM Depremin Yaralarını Sarmaya Devam Ediyor

Yakınlarını Kaybedenlere 'Yas Danışmanlığı' Yapılmalı

'Özel Çocuklar Destek Sistemi' depremzede çocuklara hizmet verecek

Deprem Korkusu Neden Olur? Nelere Dikkat Edilmeli?

İsviçre'de temel ilaç sıkıntısı yaşanıyor

Kolon Kanseri Nedir? Nelere Dikkat Edilmeli?

Büyükşehirde Yaşayanlar Daha Kaygılı ve Öfkeli

Travma Sonrası Stres Bozukluğu Neden Olur? Nelere Dikkat Etmeliyiz?

Soda mı Yoksa, Maden Suyu mu? İkisi Arasında Farklar Nelerdir?

Ara Tatilde Çocuklarda Beslenmeye Dikkat! Nelere Dikkat Edilmeli?














